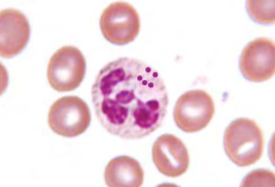
<p>name the white blood cell</p>
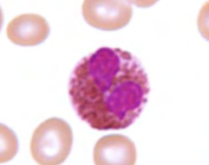
<p>name the leukocyte</p>
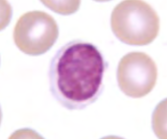
<p>name the leukocyte</p>

BIO 50B - Lab Unit 3
1/15
Earn XP
Description and Tags
Heart anatomy
Name | Mastery | Learn | Test | Matching | Spaced | Call with Kai |
|---|
No analytics yet
Send a link to your students to track their progress
16 Terms
Cardiac muscle
involuntary, mitochondrial density, intercalated discs.
intercalated discs result in
gap junctions between cells called electrical synapses that make Connexon proteins

atria
two superior atria (right and left) where blood enters the heart via veins
ventricles
two inferior ventricles (right and left) where blood exists the heart out of arteries

autorhythmic cells (pacemaker cells)
modified muscle cells (noncontractile); unstable membrane potential
What does it mean when a patient is asystole?
Heart is not contracting; their heart is not beating.

sa (sinoatrial) node
makes atrium contract
left atrium receives blood from
oxygenated blood from the lungs and pulmonary veins

valves
prevent backflow of blood
most abundant solute in blood plasma
plasma proteins (Albumin, immunoglobulins)
circle of Willis
basilar artery, cerebral arteries (6), communicating arteries (3)
name the white blood cell
neutrophil

name the leukocyte
eosinophil


name the leukocyte
basophil

name the leukocyte
lymphocyte


name the leukocyte
monocyte
